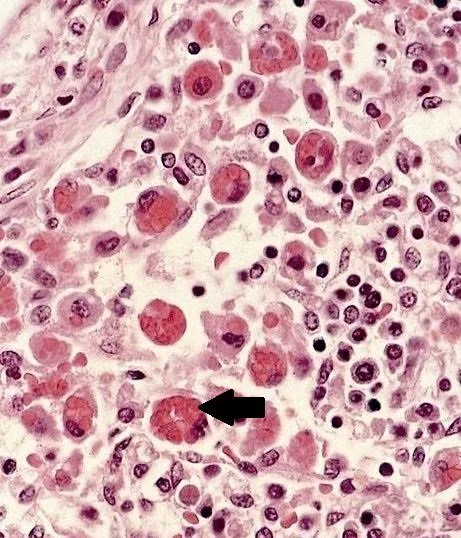

A 20 y.o. woman is referred to the ED after a diagnosis of acute leukemia is made at an OSH
She is febrile , with icterus and lymphadenopathy. She has a WBC of 3,060 with a Hgb of 9.9 . What do you notice on the slide?
atypical lymphocytes
The slide shows atypical lymphocytes. Since no diagnosis could be made a lymph node biopsy was done. It is shown below.
The lymph node biopsy showed a histiocyte (macrophage) in the process of phagocytosing RBCs. Does this represent hemophagocytic lymphohistiocytosis (HLH)?
HLH is a spectrum of disease caused by dysregulation of the immune system where natural killer and cytotoxic T cells proliferate because they are unable to kill infected cells. Infiltration of various organs of the body by mononuclear cells causes organ failure. Histiocytes proliferate as well and RBCs are phagocytized resulting in anemia and cytokine activation. A spectrum of the disease exists from a mild form to a massive cytotoxic storm. Specific criteria have been developed for HLH which include genetic testing for those with the familial form; referred to as primary HLH.
molecular diagnosis is used for the primary or hereditary forms.
Our patient met the criteria for HLH. Triglycerides were 270 mg.dL. Ferritin was high at 4,650 and fibrinogen was low at 1.4 units. All cultures were negative. The treatment for HLH is immune suppression. However, before the treatment of dexamethasone, etoposide and cyclosporine could be given she improved without treatment. This is a case of secondary HLH in a mild form. This is more likely to happen in secondary HLH than in primary HLH. In this case HLH was caused by Epstein-Barr virus and her IgM viral capsid antibody was positive for EBV..
EBV is the number one cause of viral induces HLH.
Epstein-Barr virus associated infectious mononucleosis is usually a benign syndrome characterized by proliferation of lymphomononuclear cells. Manifestations range from a non-specific constitutional syndrome to fever, rash, jaundice, hepatosplenomegaly and lymphadenopathy and rarely complications like autoimmune hemolytic anemia and neurologic disease (Bell’s palsy, meningoencephalitis and Guillain-Barre syndrome.
FUN FACTS
Although HLH is a rare condition globally it has the highest reported incidence in Japan.
95% of adults in the US have been infected with EBV and most have never had symptoms.
Gulati G, Song J, Florea A,et al. Purpose and criteria for blood smear scan, blood smear p
Chhabra P, Law A, Sharma U, et al. Epstein-Barr virus infection masquerading as acute leukemia: a report of two cases and review of literature. Indian J Hematol Blood Transfus. 2012 Oct 25;30(1):26-28.
Grose C, Henle W, Henle G, et al. Primary Epstein–Barr virus infections in acute neurologic diseases. N Engl J Med. 1975;292:392–395.
Mostaza-Fernandez J, Laso J, Ule D, et al. Hemophagocytic lymphohistiocytosis associated with viral infections: diagnostic challenge and therapeutic dilemma. Rev Clin Esp. 2014 May 19;214(6):320-327.